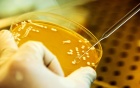

Tin tức pháp luật mới nhất 24h hôm nay ngày 3/2
(VietQ.vn) - Tin tức pháp luật mới nhất 24h hôm nay ngày 3/2 gồm ‘Nghi án cướp ngân hàng giữa ban ngày ở Hà Nội’, ‘Giang hồ đất Cảng vào miền Tây cho vay nặng lãi’,…
Sự kiện: Đọc báo mới nhất hôm nay
Tin tức pháp luật mới nhất 24h hôm nay ngày 2/2
Tin tức pháp luật mới nhất 24h hôm nay ngày 1/2
Tin tức pháp luật mới nhất 24h hôm nay ngày 31/1
Giang hồ đất Cảng vào miền Tây cho vay nặng lãi
Theo những tin tức pháp luật mới nhất hôm nay trên báo Tuổi Trẻ, vào cuối giờ chiều 1/2, Cơ quan cảnh sát điều tra tội phạm Công an TP Long Xuyên (An Giang) đã khởi tố vụ án, khởi tố bị can và bắt tạm giam Cao Hoàng Thảo, 24 tuổi ở Hải Phòng và đồng bọn về tội “Cho vay lãi nặng” theo điều 163 Bộ luật hình sự. Ba bị can còn lại là Vũ Đức Thanh (30 tuổi), Phạm Thành Trung (20 tuổi) và Hoàng Thế Mạnh (24 tuổi).
Trung tá Nguyễn Quang Vinh, Đội trưởng Đội hình sự Công an TP Long Xuyên cho biết qua nhiều ngày đấu tranh và khám xét tại nơi ở của các đối tượng lực lượng đã thu giữ hàng trăm sổ hộ khẩu, giấy CMND, bằng lái xe của hàng trăm nạn nhân ở TP.Long Xuyên, huyện Châu Thành và huyện Thoại Sơn.

Trong những tin tức pháp luật mới nhất hôm nay có vụ bắt gọn băng giang hồ đất Cảng vào An Giang cho vay nặng lãi. Ảnh Tuổi Trẻ
Bước đầu các đối tượng khai nhận vào đây từ giữa tháng 9/2015 đến nay. Ban đầu Thảo có nguồn vốn 400 triệu nhưng sau 3 tháng cho vay, con nợ đã thiếu nhóm này trên 890 triệu đồng. Thảo là người trực tiếp ghi giấy nợ và giữ giấy tờ tùy thân con nợ. Các đàn em của Thảo hàng ngày có nhiệm vụ thu tiền góp với lãi suất “khủng” từ 20 - 35%/tháng.
“Đến thời điểm này số con nợ sập bẫy nhóm cho vay nặng lãi này là 144 người. Thủ đoạn của các đối tượng là phân chia nhiệm vụ rải tờ rơi khắp nơi như cho vay gấp không cần thế chấp theo các hẻm, con đường nội ô nên nhiều người túng thiếu đã trúng bẫy!” - ông Vinh nói.
Thua bạc, nam thanh niên đi cướp tiền của trẻ bán vé số
Trao đổi với báo Dân Trí vào ngày 2/2, Cơ quan Cảnh sát điều tra Công an huyện An Phú, An Giang cho biết vừa ra quyết định khởi tố, bắt tạm giam đối với Trần Văn Ổn (sinh năm 1987, trú tại ấp Đồng Ky, xã Quốc Thái, huyện An Phú) về hành vi “Cướp tài sản”.
Trước đó, khoảng 9h ngày 23/01, Ổn sang Campuchia đánh bạc thua hết tiền. Ổn gặp em Nguyễn Minh Nhớ (sinh năm 2000, trú tại xã Vĩnh Hậu, huyện An Phú) đang bán vé số trong trường gà, biết em Nhớ có tiền nên Ổn nảy sinh ý định chiếm đoạt.

Đối tượng Ổn và tang vật khi bị cơ quan Công an bắt giữ. Ảnh Dân Trí
Lúc này, Ổn lừa em Nhớ đến đoạn đường vắng thuộc ấp Quốc Phú, xã Quốc Thái, huyện An Phú, Ổn dùng tay siết cổ Nhớ rồi chiếm đoạt trên 1,5 triệu đồng tiền bán vé số của em. Sau đó, Ổn dùng tiền vừa cướp được đi chuộc chiếc xe mà Ổn đem cầm trước đó. Ổn chạy đến ấp Phước Hòa, xã Phước Hưng, huyện An Phú thì bị lực lượng Công an bắt giữ.
Nghi án cướp ngân hàng giữa ban ngày ở Thủ đô
Trưa 3/2, sau tiếng hô hoán báo cướp của nhân viên phòng giao dịch số 6 thuộc Ngân hàng Nông nghiệp và Phát triển Nông thôn Việt Nam (Agribank) trên phố Trần Đại Nghĩa (Hà Nội), nhiều người nhìn thấy hai nam thanh niên bịt khẩu trang cầm hung khí tháo chạy từ đây ra đường, vội vàng lên một chiếc xe máy không biển số phóng bỏ chạy.

Nhiều cảnh sát được cử đến phòng giao dịch số 6 của Agribank để thực thi nhiệm vụ. Ảnh Otofun
Đại diện Phòng Cảnh sát hình sự Hà Nội cho hay ngay khi nhận được tin báo đã cử cán bộ tới hiện trường, huy động nhiều lực lượng làm rõ sự việc. Trao đổi với VnExpress, bà Nguyễn Thị Phượng (Phó tổng giám đốc Agribank) cho hay theo tin báo của phòng giao dịch này, vào buổi trưa có hai nam thanh niên xô xát với bảo vệ của ngân hàng, khiến xảy ra lộn xộn. "Không ai bị thương và tài sản của ngân hàng không bị mất", bà Phượng nói.
Trong chiều nay, phòng giao dịch này vẫn hoạt động bình thường. Agribank đang phối hợp với Công an quận Hai Bà Trưng trích xuất dữ liệu camera để xác minh vụ việc.
Lan Anh (T/h)